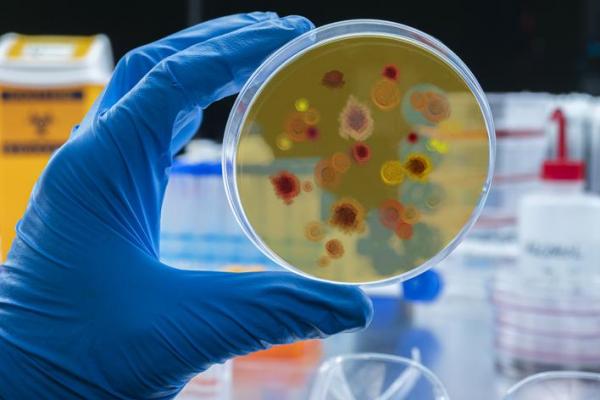

-
Todos
- Online
-
Filtros
Masters de Medicina preventiva

- Master
- Online
- Fechas a elegir
- 1500h - 12 Meses
Con el presente Master en Medicina Preventiva recibirá una formación especializada en la materia. En materia de salud, llevar a cabo acciones para prevenir enfermedades es de vital importancia para garantizar la salud pública, con el presente Master en Medicina Preventiva conocerá todo lo relacionado con la medicina preventiva.


-
Es carisimo, pero Te prometen becas y te atienden muy bien antes de matricularte. Cuando te matrículas es todo caótico y no hay quien te atienda a dudas, no responden mail los tutores, y si preguntas por las becas, te aseguran que eso no es con ellos.
← | →
-
Estudiar requiere de mucha constancia y fuerza de voluntad si compaginas la formación con el trabajo. Creo que hay aspectos en los que el máster podría mejorar, pero estoy satisfecho. He conocido un montón de compañeros de los que he aprendido mucho.
← | →
- Master oficial
- Online
- 1 Año
La sociedad actual requiere de respuestas innovadoras y adaptadas a las necesidades y expectativas de unas poblaciones en plena transición global. Ante esto, la situación laboral precisa de profesionales muy bien formados en métodos de análisis de datos en salud y con una comprensión global de los sistemas sanitarios.
La sociedad actual requiere de respuestas innovadoras y adaptadas a las necesidades y expectativas de unas poblaciones en plena transición global. Ante esto, la situación laboral precisa de profesionales muy bien formados en métodos de análisis de datos en salud y con una comprensión global de los sistemas sanitarios.
-
Es carisimo, pero Te prometen becas y te atienden muy bien antes de matricularte. Cuando te matrículas es todo caótico y no hay quien te atienda a dudas, no responden mail los tutores, y si preguntas por las becas, te aseguran que eso no es con ellos.
← | → ver todas
-
Estudiar requiere de mucha constancia y fuerza de voluntad si compaginas la formación con el trabajo. Creo que hay aspectos en los que el máster podría mejorar, pero estoy satisfecho. He conocido un montón de compañeros de los que he aprendido mucho.
← | → ver todas

-
Lo recomiendo.
← | →
- Master
- Online
- Fechas a elegir
- 710h - 12 Meses
- Curso bonificable
¿Te gustaría enfocar tu desarrollo profesional en el área del servicio al cliente y la hostelería? No hay mejor momento para empezar con esta formación. Emagister te presenta el Máster en Técnicas de Recepción y Atención al Cliente en Alojamientos más Titulación Universitaria, diseñado y desarrollado por el centro Educa Business School en su modalidad online y con una...
¿Te gustaría enfocar tu desarrollo profesional en el área del servicio al cliente y la hostelería? No hay mejor momento para empezar con esta formación. Emagister te presenta el Máster en Técnicas de Recepción y Atención al Cliente en Alojamientos más Titulación Universitaria, diseñado y desarrollado por el centro Educa Business School en su modalidad online y con una...
-
Lo recomiendo.
← | →

- Master
- Online
- Fechas a elegir
- 600h
Este Master en Medicina Preventiva y Salud Pública, MMP desarrolla un programa de calidad, con un contenido totalmente actualizado y un diseño atractivo, ofrece un amplio programa sobre Medicina Preventiva Salud Pública.

- Master
- Online
- Fechas a elegir
- 1500h - 12 Meses
¿Buscas una especialización para mejorar tu perfil profesional? Con este máster te preparas para desempeñar la función de un odontólogo en clínicas veterinarias, adquiriendo todas las habilidades y técnicas de exploración clínica necesarias para desarrollar esta labor. En esta línea, te capacitas para identificar y tratar enfermedades en la cavidad oral de los animales...

-
Ser tecnico veterinario es fundamental para poder ayudar de manera correcta alos animales. Esta escuela me brindó las herramientas suficientes para llevar acabo está tarea, pues cuentan con una excelente metodología de enseñanza.
Muchas Gracias.
← | →
- Master
- Online
- Fechas a elegir
- 600h - 1 Año
¿Quieres conviértete en especialista multidisciplinario para el entendimiento, desarrollo cuidado de los animales? Esta es tu oportunidad, Emagister te ofrece el curso Auxiliar técnico de veterinaria, diseñado por expertos del prestigioso centro Esneca Business School, el cual lo dispone en una modalidad de estudio online, y esto te proporciona la oportunidad de poder...
¿Quieres conviértete en especialista multidisciplinario para el entendimiento, desarrollo cuidado de los animales? Esta es tu oportunidad, Emagister te ofrece el curso Auxiliar técnico de veterinaria, diseñado por expertos del prestigioso centro Esneca Business School, el cual lo dispone en una modalidad de estudio online, y esto te proporciona la oportunidad de poder...
-
Ser tecnico veterinario es fundamental para poder ayudar de manera correcta alos animales. Esta escuela me brindó las herramientas suficientes para llevar acabo está tarea, pues cuentan con una excelente metodología de enseñanza.
Muchas Gracias.
← | →

-
lo mejor de la formación es el material muy estructurado y muy completo, trae una información muy concisa y clara , todo paso por paso y es bien fácil de seguir
← | →
- Postgrado
- Online
- Fechas a elegir
- 300h - 1 Año
- Prácticas en empresa
¡Desarrolla tus habilidades y enriquece tus conocimientos! Desde Emagister te facilitamos el acceso a la inscripción al Postgrado Experto en Epidemiología que ofrece la Escuela de Posgrado en Medicina y Sanidad. Contiene un amplio catálogo donde encuentras diferentes opciones que te van a brindar las herramientas para afrontar las demandas laborales actuales. Este curso...
¡Desarrolla tus habilidades y enriquece tus conocimientos! Desde Emagister te facilitamos el acceso a la inscripción al Postgrado Experto en Epidemiología que ofrece la Escuela de Posgrado en Medicina y Sanidad. Contiene un amplio catálogo donde encuentras diferentes opciones que te van a brindar las herramientas para afrontar las demandas laborales actuales. Este curso...
-
lo mejor de la formación es el material muy estructurado y muy completo, trae una información muy concisa y clara , todo paso por paso y es bien fácil de seguir
← | →

- Master
- Online
- Fechas a elegir
- 600h - 1 Año
¡Adéntrate en el apasionante mundo de la veterinaria con el exclusivo Máster en Ayudante Técnico Veterinario! Disponible en la reconocida plataforma Emagister y ofrecido en modalidad online, este programa te brinda la oportunidad de convertirte en un profesional capacitado para asistir en la atención veterinaria y el cuidado de animales. No dejes pasar esta oportunidad...
-
No conozco mucho sobre esta tematica, asi que me parece un curso muy interesante.
← | →
- Diploma de Especialización
- Online
- Fechas a elegir
¿Te gustaría profundizar tus conocimientos en el área del bienestar y salud? ¿Poder ayudar a cientos de personas a través de tu preparación? Si es así, has llegado al lugar indicado. Se trata del Diplomado en Digitopuntura + Acupuntura que el centro MONTSERRAT IBEROAMERICANO ha desarrollado especialmente para ti de forma online.
¿Te gustaría profundizar tus conocimientos en el área del bienestar y salud? ¿Poder ayudar a cientos de personas a través de tu preparación? Si es así, has llegado al lugar indicado. Se trata del Diplomado en Digitopuntura + Acupuntura que el centro MONTSERRAT IBEROAMERICANO ha desarrollado especialmente para ti de forma online.
-
No conozco mucho sobre esta tematica, asi que me parece un curso muy interesante.
← | →

- Master
- Online
- Fechas a elegir
- 1500h - 12 Meses
El Máster en Medicina Dental Veterinaria te ofrece la oportunidad de sumergirte en un sector en pleno auge, donde la demanda de profesionales cualificados no deja de crecer. En un entorno cada vez más concienciado con la salud y el bienestar animal, especializarte en esta área te permitirá adquirir habilidades únicas y esenciales. A través de un enfoque integral, el máster...

- Master
- Online
- Fechas a elegir
- 600h
El propósito de la titulación de Máster Degree es ofrecer un conocimiento profundo y concentrado de una especialidad. Los estudiantes deben demostrar que dominan de forma práctica y efectiva las materias directamente relacionadas con dicha especialidad. Estos conocimientos especializados y prácticos están muy demandados en el mundo laboral, lo que ha dotado a este nivel...

- Master
- Online
- Fechas a elegir
- 1500h
Emagister.com y la Universidad de los Pueblos de Europa (UPE) ofrecen el Máster en medicina preventiva y salud pública (MMP), dirigido a profesionales de la salud en medicina preventiva y la salud pública. El máster tiene una duración de 600 horas, se imparte a distancia y los horarios son flexibles, lo que permite compaginarlo con la actividad laboral.

- Postgrado
- Online
- Fechas a elegir
- 300h
El curso Higiene en el Medio Hospitalario, del centro EDUCAMIX EDUCACIÓN ON LINE DE ÚLTIMA GENERACIÓN, se ha añadido al catálogo formativo de emagister.com. La formación tiene como objetivo proporcionar, al personal de enfermería, una herramienta útil que aumente la calidad de su actividad asistencia, en campos relacionados con la prevención de enfermedades trasmisibles...

- Doctorado
- Online
- Fechas a elegir
- 1750h
El Doctor Degree constituye el máximo nivel de especialización que podemos obtener en cualquier campo. Los estudiantes deben demostrar un dominio absoluto de su especialidad y plasmar este conocimiento en una tesis en la que desarrollan sus argumentos, defienden sus ideas y reflejan sus conclusiones sobre la materia.

- Postgrado
- Online
- Fechas a elegir
- 300h
Postgrado de Experto en Higiene y Medicina Preventiva Hospitalaria, PEX, proporciona, al personal sanitario, una herramienta útil que aumente la calidad de su actividad asistencia, en campos relacionados con la prevención de enfermedades trasmisibles, desinfección y esterilización de material sanitario de distinta índole. Además de conocer los elementos de la cadena epidemiológica...

- Master
- Online
- Fechas a elegir
- 1500h
Ciencias de la Salud es la disciplina que proporciona los conocimientos adecuados para la promoción de la salud y el bienestar tanto del individuo como de la colectividad. Entraña un conjunto de diferentes disciplinas (ciencias aplicadas) que están orientadas o se dedican a la salud de seres humanos y animales.

- Master
- Online
- Fechas a elegir
- 600h
Master en Salud Pública y Desarrollo Social es un programa orientado a la formación de profesionales capacitados para trabajar en el fortalecimiento de la Salud Pública, la cual se proyecta e integra al desarrollo social como un eje indispensable para generar progreso y desarrollo desde las ciencias sociales, humanas y de la salud.

- Master
- Online
- Fechas a elegir
- 600h
CIU Cambridge International University los programas de maestría están diseñados para el reconocimiento del valor de la experiencia laboral de los adultos aportando curricularmente acreditaciones que valoren su cultura, trabajo y experiencia vivida.

- Postgrado
- Online
- Fechas a elegir
- 750h
Si tienes formación en el campo de la Medicina y quieres adquirir nuevos conocimientos en el campo de las prácticas y terapias propias de la Medicina Natural, no dejes pasar esta formación. El centro EDUCAMIZ GROUP imparte la formación de Postgrado en Medicina Natural, una formación específica que te permitirá aplicar las terapias de medicina alternativa.

- Master
- Online
- Fechas a elegir
- 1500h
Si quieres especializarte en otra rama de la medicina, Emagister te trae este novedoso programa educativo, el Master en medicina aeroespacial, MMA, que ayudará a comprender las alternativas que pueden aparecer en el ser humano cuando se somete a las condiciones de un medio que le es extraño. Esta formación se imparte en modalidad online por parte del centro educativo Educamix...

- Master
- Online
- Fechas a elegir
- 1500h
La salud pública es el pilar central de estudio de los profesionales de la salud, es por esto que a través de este Máster Profesional en Salud Pública, MPS se quiere mostrar los conceptos de la misma, y de este modo identificar la relación existente entre salud y ecología.

- Master
- Online
- Fechas a elegir
- 1500h
El propósito de la titulación de Máster Degree es ofrecer un conocimiento profundo y concentrado de una especialidad. Los estudiantes deben demostrar que dominan de forma práctica y efectiva las materias del Master of Science in Public Health and Social Development, M.Sc., especializados y prácticos están muy demandados en el mundo laboral, lo que ha dotado a este nivel...

- Diploma de Especialización
- Semipresencial en Madrid
- 6 Meses
Entre el 75-80% de las úlceras en extremidad inferior tienen un componente venoso. Su origen multifactorial requiere un enfoque holístico, combinando un adecuado cuidado local de las heridas con un tratamiento etiológico basado en la terapia compresiva. Este postgrado forma a los profesionales de la salud en el abordaje integral de las Úlceras Venosa.
Preguntas & Respuestas
Añade tu pregunta
Nuestros asesores y otros usuarios podrán responderte


